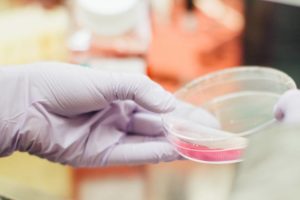
laborfleisch - ernaehrung der zukunft

Welche Lebensmittel sollten Bio sein?

Biologisch angebaute Lebensmittel sind häufig etwas teurer als konventionelle Nahrungsmittel. Doch bei einigen Frucht- und Gemüsesorten lohnt es sich die teureren Bio-Produkte zu kaufen, da einige Lebensmittel besonders stark mit Pestiziden belastet sind. In diesem Artikel erfahren Sie, welche Lebensmittel Bio sein sollten. In meinem zweiten Artikel liste ich die Lebensmittel auf, die nicht Bio sein müssen.
Dirty "Dozen" Liste für Deutschland: Diese Lebensmittel sollten Bio sein
Auf der englischsprachigen Website ewg.org gibt es eine, Liste die die Lebensmittel aufzählt, die eine besonders hohe Pestizidbelastung aufweisen. Die Liste nennt sich Dirty Dozen. Dort wurden Lebensmittel getestet die für den amerikanischen Markt bestimmt sind und größtenteils auch für Deutsche Lebensmittel gelten. Kleine geringfügige Unterschiede für den Deutschen Markt gibt es dennoch. Greenpeace hat einen Ratgeber herausgebracht, der belastete und unbelastete Lebensmitteln untersucht, die für den deutschen Markt bestimmt sind. Sozusagen eine Clean Fifteen & Dirty Dozen Liste für Deutschland. Der volle Ratgeber „Essen ohne Pestizide“ kann kostenlos hier angeschaut werden.
Liste der Früchte, die auf grund hoher Pestizidbelastung in Bio-Qualität gekauft werden sollten:




























Liste der Gemüsesorten, die auf Grund hoher Pestizidbelastung in Bio-Qualität gekauft werden sollten:
























5 Regeln um Pestizide zu meiden
Je nach Region und Jahreszeit gibt es nicht immer biologisch angebautes Obst oder Gemüse. Dann bleibt nur der Griff zu konventionell angebauten Lebensmitteln. Trotzdem können gewisse Regeln befolgt werden, um die Einnahme von Pestiziden in Lebensmitteln zu minimieren.
1. Bio ist geringer belastet
Wann immer es geht, sollte Bio Obst & Gemüse gekauft werden. Besonders bei stark belastetem Obst & Gemüse sollten Bio-Produkte bevorzugt werden.
2. Auf Herkunftsland achten
In Deutschland angebautes Gemüse ist häufig weniger mit Pestiziden belastet. Allerdings gilt dies nicht für alle Lebensmittel. Auch bei belasteten Lebensmitteln sollten deutsche Produkte bevorzugt werden, da in Deutschland teilweise strengere Gesetze gelten, als in anderen Ländern.
3. Eine dicke Schale schützt
Frucht- & Gemüsesorten mit einer dicken Schale enthalten weniger Pestizide im inneren. Im Schnitt sind also konventionelle Lebensmittel mit dicker Schale geringer belastet.
4. Seife verwenden
Früchte und Gemüse mit warmen Wasser und einer neutralen Seife ohne Geruchs oder Farbstoffe waschen. Der Großteil der Pestizide befindet sich außen und ist fettlöslich. Dadurch kann ein großer Teil der Pestizide einfach abgewaschen werden.
5. Obst ist stärker belastet
Die meisten Obstsorten sind stärker mit Pestiziden belastet als Gemüse. Das liegt einerseits am höheren Zuckergehalt (dadurch vermehrte Anwendung von Pestiziden) und andererseits an einer dünnen Schale. Vermutlich spielen die Anbauländer auch eine Rolle. Deshalb vor allem bei Obst lieber zu Bio-Produkten greifen.
Zusammenfassung: Die oben aufgeführten Lebensmittel sind teilweise stark mit Pestiziden belasten und sollten wann immer möglich als Bio-Produkte gekauft werden. Dabei sind häufig Beeren, Zitrusfrüchte mit Pestiziden belastet. Besonders stark sind Äpfel, Erdbeeren, Trauben, Pfirsiche, Sellerie und Kopfsalat belastet. Diese Produkte sollte man, wann immer es geht, in Bio-Qualität kaufen. Zudem können die oben abgebildeten Regeln eingehalten werden um zusätzlich die Einnahme von Pestiziden zu vermeiden. In diesem Artikel erfahren Sie, welche Lebensmittel eher gering belastet sind und daher auch auf konventionell angebaute Produkte zurückgegriffen werden kann.